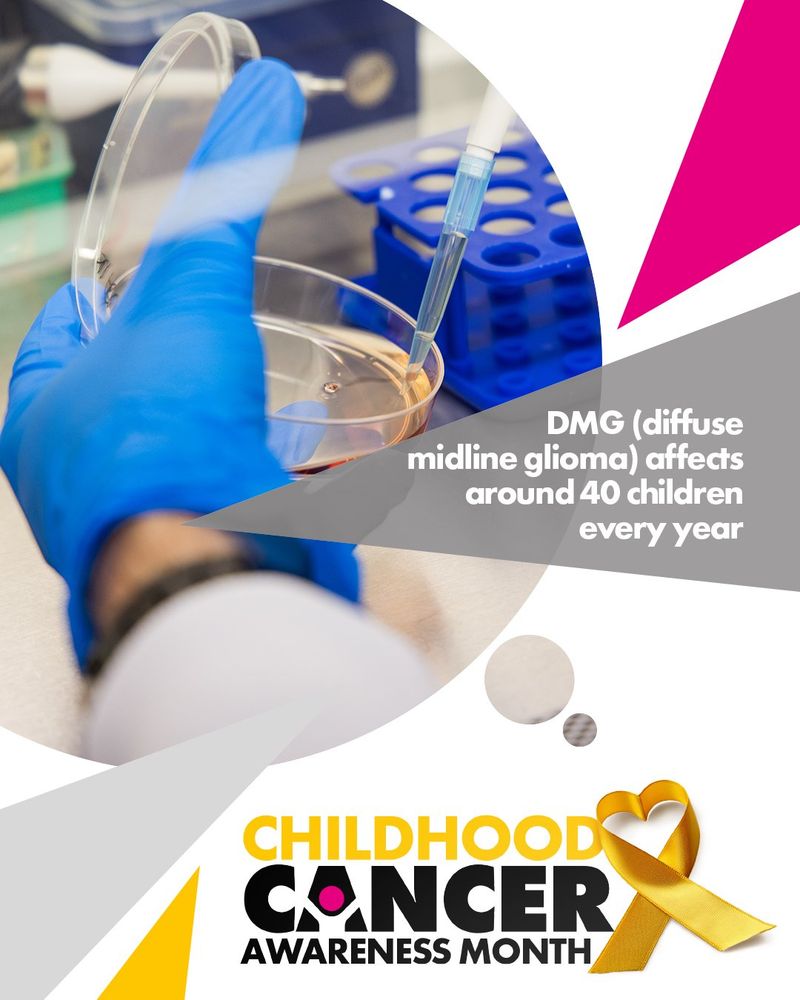

Brain Tumour Research
@braintumourrsch.bsky.social
640 followers
1.3K following
270 posts
💛 Our Vision - To find a cure for all types of brain tumours
💛 Our Mission - To increase the UK investment in research into brain tumours
http://www.braintumourresearch.org
Posts
Media
Videos
Starter Packs
Reposted by Brain Tumour Research
Reposted by Brain Tumour Research
Reposted by Brain Tumour Research